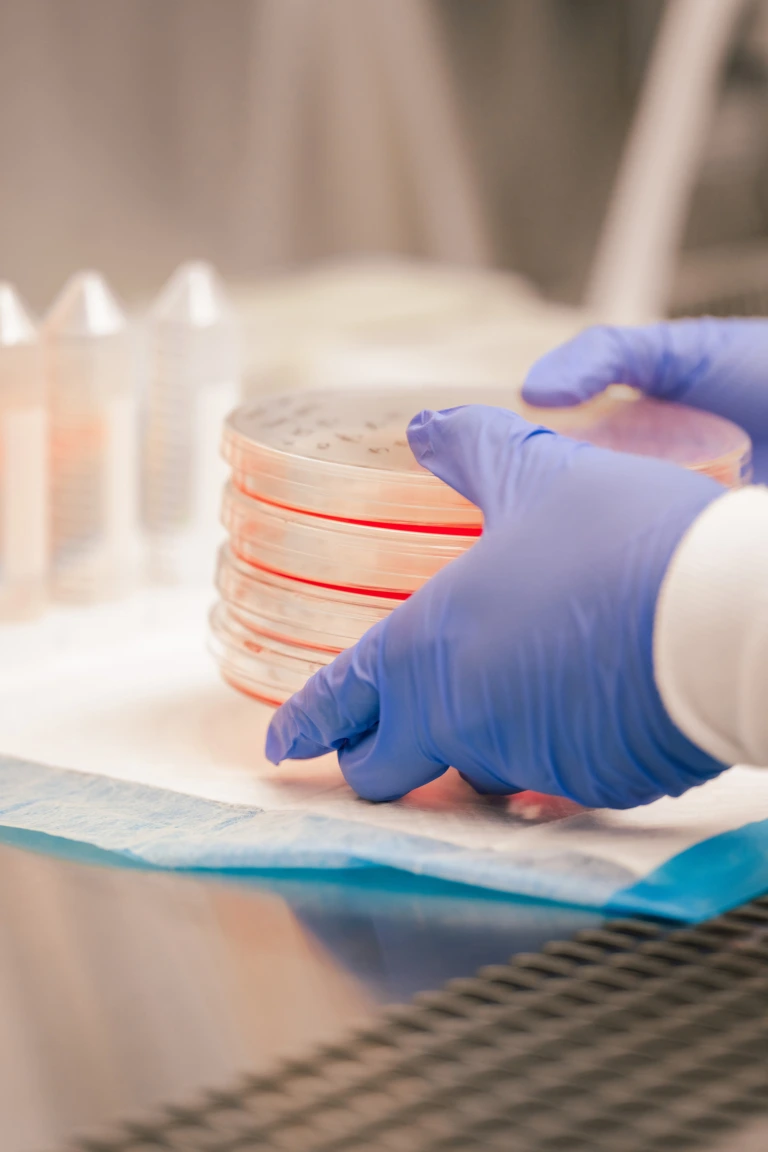
Gloved hands holding a stack of petri dishes with red agar in a laboratory setting.

%20(1).webp)
Our fundamental purpose is to develop new immunotherapies to defy cancer and help patients thrive.
We believe in improving lives. We believe in scientific rigor and disciplined execution
We believe in science requires a trailblazing spirit.

%20(1).webp)
We believe in improving lives. We believe in scientific rigor and disciplined execution
We believe in science requires a trailblazing spirit.